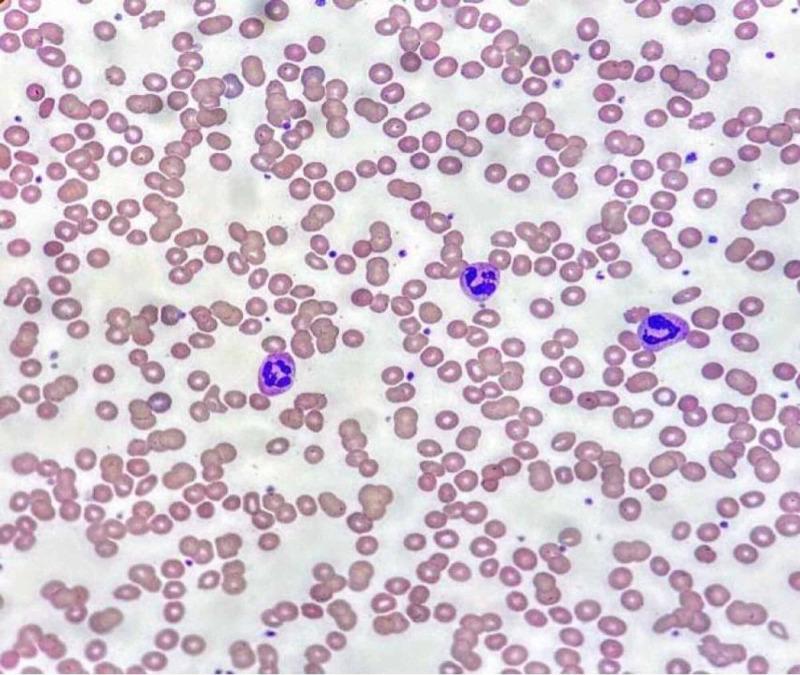
https://cdn.ncbi.nlm.nih.gov/pmc/blobs/e822/7885958/5b89d294e1b1/cureus-0013-00000012751-i02.jpg

一名新冠肺炎患者体内的短暂性冷凝集素
Transient Cold Agglutinins in a Patient With COVID-19.
作者信息
Kaur Jasmeet, Mogulla Swathi, Khan Rafiullah, Krishnamoorthy Geetha, Garg Sandeep
机构信息
Internal Medicine, St. Joseph Mercy Oakland Hospital, Pontiac, USA.
Hematology and Oncology, University of Cincinnati Medical Center, Cincinnati, USA.
出版信息
Cureus. 2021 Jan 17;13(1):e12751. doi: 10.7759/cureus.12751.
Coronavirus disease 2019 (COVID-19) infection has been associated with various complications such as acute respiratory distress syndrome, acute kidney failure, myocardial infection, and thromboembolism. Cold agglutinin syndrome (CAS) has been associated with other viral infections such as Epstein-Barr virus (EBV), but there have been only a few reports of cold agglutination associated with COVID-19. In this report, we describe a case of transient cold agglutinin elevation in a COVID-19-infected patient. A 61-year-old man with hypertension, diabetes mellitus, and end-stage renal disease (ESRD) presented with shortness of breath, cough, and lethargy for five days. A clinical diagnosis of COVID-19 infection was made. The COVID-19 RNA qualitative real-time polymerase-chain-reaction (PCR) assay tested positive. During the hospital stay, he had progressive dyspnea requiring intubation and mechanical ventilation. During the third week of hospital stay, an acute drop in the hemoglobin (Hb) level to 4.5 g/dl (baseline Hb: 9 g/dl) was observed. The workup for acute anemia revealed a positive result for cold agglutinins, direct antibody test (C3d), and agglutination of the red blood cells were apparent on the peripheral blood smear. Further, cold agglutinin titers peaked during the third week of the onset of illness and significantly declined during the fifth week. These observational findings indicate that cold agglutinin titers might correlate with the disease activity.
2019冠状病毒病(COVID-19)感染与多种并发症相关,如急性呼吸窘迫综合征、急性肾衰竭、心肌感染和血栓栓塞。冷凝集素综合征(CAS)与其他病毒感染如爱泼斯坦-巴尔病毒(EBV)有关,但与COVID-19相关的冷凝集现象仅有少数报道。在本报告中,我们描述了一例COVID-19感染患者出现短暂冷凝集素升高的病例。一名61岁男性,患有高血压、糖尿病和终末期肾病(ESRD),出现气短、咳嗽和嗜睡5天。临床诊断为COVID-19感染。COVID-19 RNA定性实时聚合酶链反应(PCR)检测呈阳性。住院期间,他出现进行性呼吸困难,需要插管和机械通气。住院第三周,观察到血红蛋白(Hb)水平急剧下降至4.5 g/dl(基线Hb:9 g/dl)。急性贫血检查显示冷凝集素、直接抗体试验(C3d)结果呈阳性,外周血涂片可见红细胞凝集。此外,冷凝集素滴度在发病第三周达到峰值,并在第五周显著下降。这些观察结果表明冷凝集素滴度可能与疾病活动相关。